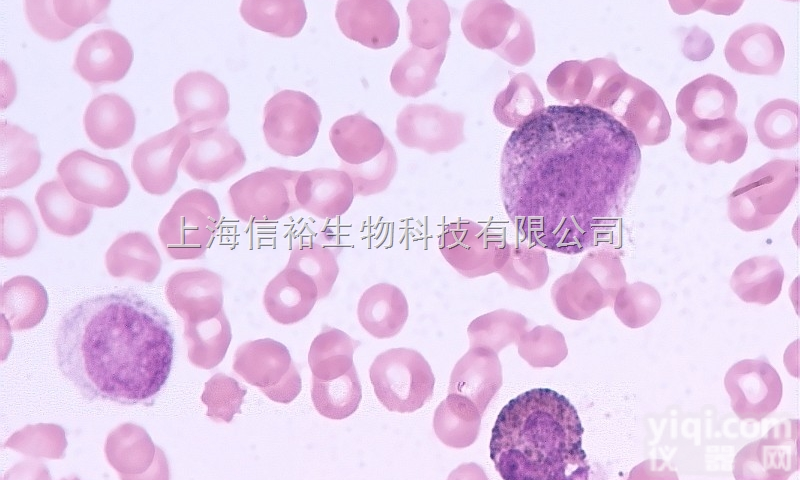
NCI-H292（<em>肺癌</em><em>细胞</em>（<em>淋巴结</em>转移）

产品信息
NCI-H292(肺癌细胞(淋巴结转移))
低价销售中
产品注意:细胞在三期中的任何一期(一般发生在传代后期或衰退期)在某些因素影响下,如血清质量不佳、病毒污染、温度和pH不稳等,细胞可能发生自发转化(spontaneous transformation);
公司NCI-H292(肺癌细胞(淋巴结转移)) 相关产品:
FS-D0588 氟比洛芬酯 对照品 含量测定 100696-200401 200mg
FS-D05886A 苄达赖氨酸杂质A(3-羟基-1-苄基吲唑) 对照品 TLC检查 100701-200401 50mg
FS-D05887A 盐酸舍曲林 对照品 HPLC法含量测定 100702-200401 50mg
FS-D05888A 马来酸依那普利 对照品 HPLC法含量测定 100705-200401 100mg
FS-D05889A 依那普利双酮 对照品 HPLC检查 100706-200401 30mg
FS-D05890A 依那普利拉 对照品 HPLC系统适应性检查 100707-200401 30mg
FS-D05891A 氯化钾 对照品 原子吸收分光光度法含量测定用 100708-200401 100mg
FS-D05892A 兰索拉唑 对照品 含量测定(HPLC) 100709-200501 100mg
FS-D05893A 富马酸比索洛尔 对照品 HPLC法含量测定 100711-200401 100mg
FS-D05894A 马来酸氨氯地平 对照品 HPLC法含量测定 100712-200401 100mg
FS-D0589 丁苯羟酸 对照品 含量测定(HPLC) 100714-200501 100mg
FS-D05896A 盐酸苯环壬酯杂质(N-甲基-3-氮苯双环(3,3,1)壬-9α醇) 对照品 检查(TLC) 100715-200501 50mg
FS-D05897A 盐酸苯环壬酯 对照品 含量测定(HPLC) 100716-200501 50mg
FS-D05898A 非洛地平 对照品 含量测定(UV) 100717-200501 100mg
FS-D05899A 酒石酸托特罗定 对照品 HPLC法含量测定 100723-200401 50mg
FS-D05900A 丁二酸(琥珀酸)洛沙平 对照品 TLC法鉴别 100724-200401 100mg
FS-D05901A 氟比洛芬 对照品 TLC法、HPLC法有关物质检查 100725-200401 50mg
FS-D05902A 盐酸阿唑嗪 对照品 含量测定(UV) 100728-200501 100mg
FS-D05903A 盐酸丁咯地尔 对照品 HPLC法含量测定 100729-200401 100mg
FS-D05904A 卡维地洛 对照品 HPLC法含量测定 100730-200401 100mg
FS-D0590 阿维A 对照品 HPLC法含量测定 100731-200401 50mg
FS-D05906A 苯扎贝特 对照品 UV法含量测定 100732-200501 100mg
FS-D05907A 非诺贝特 对照品 UV法含量测定 100733-200401 50mg
FS-D05908A 苯甲酸甲硝唑 对照品 UV法含量测定 100734-200401 100mg
FS-D05909A 醋酸钠 对照品 HPLC法含量测定 100735-200401 50mg
FS-D05910A 葡萄糖酸钠 对照品 HPLC法含量测定 100736-200401 50mg
FS-D05911A 盐酸索他洛尔 对照品 含量测定(HPLC) 100737-200501 100mg
FS-D05912A 拉西地平 对照品 UV法含量测定 100741-200501 100mg
FS-D05913A 尼麦角林 对照品 含量测定 100742-200501 100mg
FS-D05914A 盐酸赛洛唑啉 对照品 HPLC法含量测定 100744-200401
FS-D0591 磷酸二氢钾 对照品 比色法含量测定 100745-200401 100mg
FS-D05916A 长春胺 对照品 含量测定(UV) 100747-200501 100mg
指数增生期(logarithmic growth phase):
特点:细胞增殖旺盛阶段,分裂相增多。
细胞分裂指数(mitotie index MI) :表示每1000个细胞中的分裂相数。
条件:分裂相数与细胞种类、培养成分、pH培养箱温度有关。
细胞分裂指数:初代细胞:在0.1%~0.5%之间% ,
推荐培养基:高糖DMEM或者1640培养基+10%进口胎牛血清
品Pai:ATCC,ScienCell公司
规格:一株
![[<em>细胞</em>及相关培养] ATCC引进<em>细胞</em> NCI-H292(<em>肺癌</em><em>细胞</em>(<em>淋巴结</em>转移)](https://item.yiqi.com/pic/CovPic/1/201082316218319.jpg)